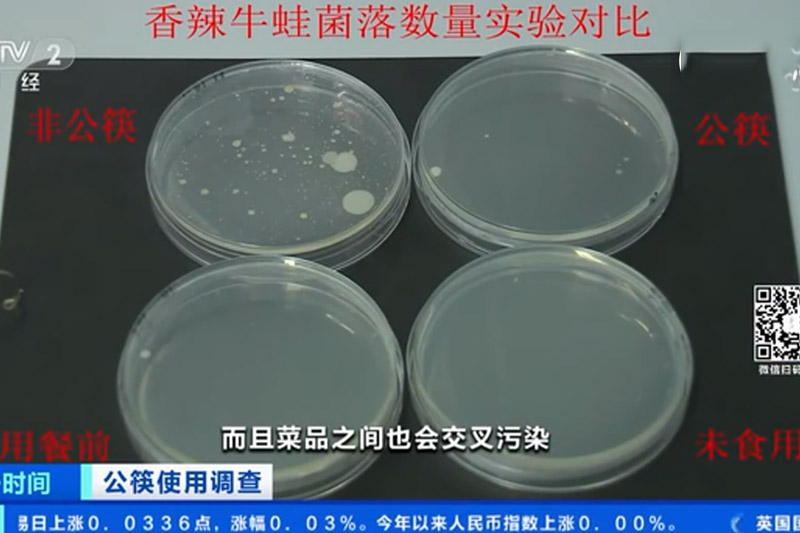

【用公筷好處】內地實測:不用公筷夾餸細菌量多909倍

編輯: Fion
日期: 2021-01-02

新冠疫情持續,不少人的生活習慣都有所改變,包括在外出周餐時,都習慣使用公筷及公羹,為的是防止感染及傳染病的散播。內地媒體報道,比對在使用公筷和不使用公筷情況下進行實驗,發現有餸菜的菌落總數,兩個組別最多相差909倍。
2617次閱讀